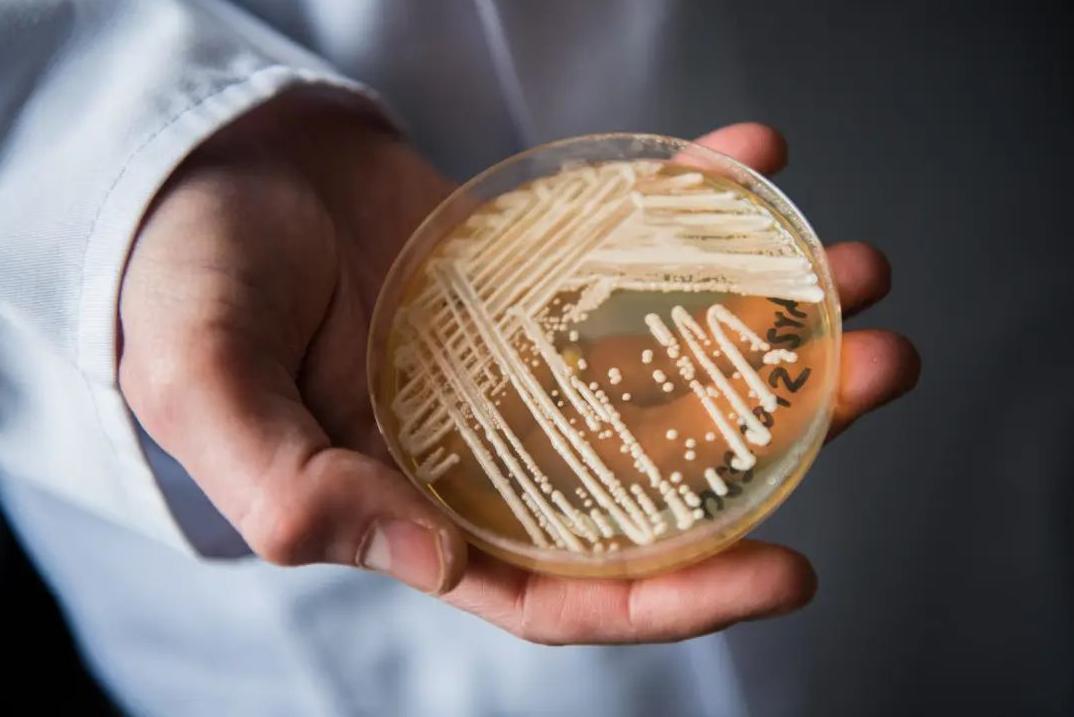
阿根廷传染病事件,澳大利亚发现最致命真菌
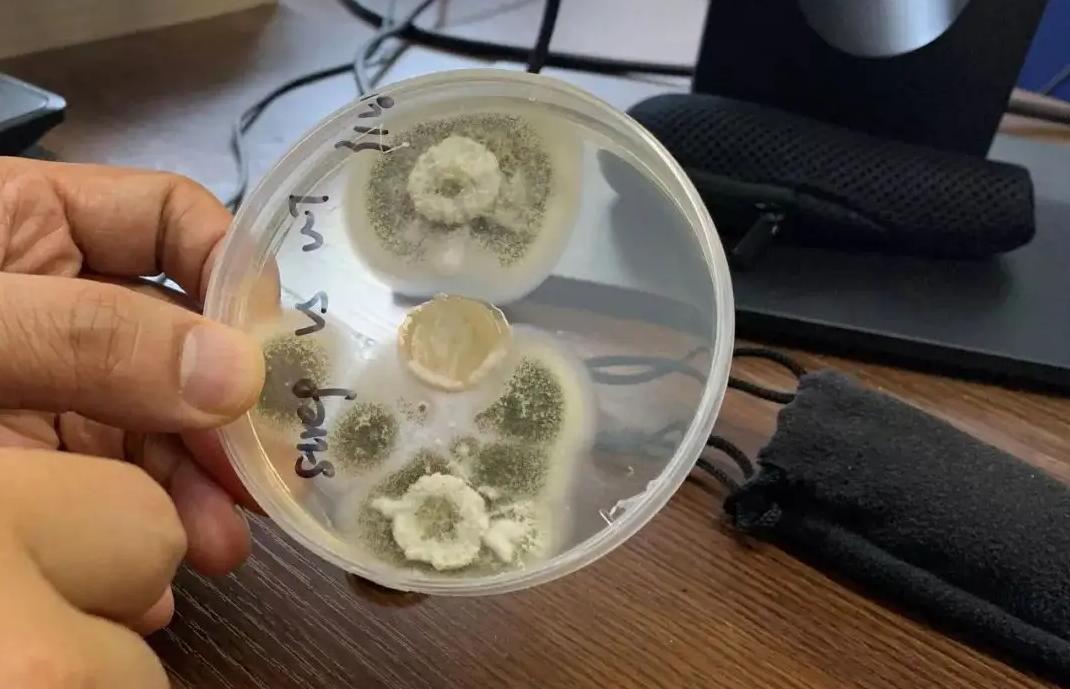
阿根廷传染病事件,澳大利亚发现最致命真菌

根据报道:近日在阿根廷首都发现了2例“超级真菌”感染病例,这也是阿根廷第一次发现此类传染病。
据悉,这两名感染者虽然都生活在同一个城市,但是彼此却并不相识,生活轨迹也没有任何的交集,因此,尚不清楚他们是在何时、何地感染的“超级真菌”。
这则消息发布后,很快就引起了不少人的恐慌,因为从名字来看,“超级真菌”就给人一种很可怕的感觉,所以,不少网友都担心,这会不会是又一场疫情大流行。
那么,究竟什么是“超级真菌”?它为何会出现在阿根廷呢?
今天给大家圈出个有用的知识点:什么是超级真菌?
喜欢使者的朋友,欢迎点击一键三连
超级真菌,学名为“耳念珠菌”,它是一种致死率约为60%的真菌,最早是在2009年的时候,一名日本医生在给患者进行外耳道治疗的时候,从病人的耳道分泌物中,发现了这种可怕的真菌。
之后,全球其他国家也都开始陆续有“超级真菌”的感染病例,截止到目前,全球已有40多个国家,都曾出现过“超级真菌”的感染者,累计病例更是高达5000人。所以,这一次阿根廷会发现“超级真菌”,其实也并不奇怪,因为在人类尚无法将其彻底消灭的情况下,在未来的确会有更多的国家,都出现“超级真菌”的感染病例。
从资料上来看,在所有出现“超级真菌”感染者的国家中,累计感染人数最多的一个国家就是美国,和其他国家只有几个,或者是几十个感染病例不同,自从2016年美国发现了第一例“超级真菌”感染者后,短短6年的时间里,美国的感染病例已经占到全球的20%以上。
至于为何美国的“超级真菌”感染者众多,尤其是2019年之后,美国“超级真菌”感染者更是呈现倍数上升,有美国研究者认为,或许是因为新冠疫情导致美国医院人满为患,这也给“超级真菌”的传播,提供了很好的机会,所以,它才会在美国迅速传播,让人防不胜防。

那么,“超级真菌”是如何感染人类的?它会成为下一场疫情大流行吗?
其实啊,对于身体健康的人群来说,“超级真菌”并不可怕。虽然“超级真菌”致死率高,而且也很容易造成传播,但是,它的主要传播地点却是在医院,感染人群也普遍都是免疫力低下的患病人群,由此可见,它想成为下一场大流行并没有那么容易,毕竟,“超级真菌”离开了医院,它的传播链条就会断掉,因此,大家不用对它感到过分惊慌。
那么,“超级真菌”又是如何出现的呢?
经过多年的研究,有专家认为,“超级真菌”的出现,或许与全球变暖有关,有观点认为,它可能是某种尘封的古老真菌,随着温室效应的加剧,又开始出现在自然界里。
也有研究者认为,“超级真菌”的出现与农业发展有关,认为是农业生产过程中对于“杀真菌剂”的滥用,才会导致自然界里的某种真菌,发生了变异,演化成了“超级真菌”,这也可以解释,为何它具有极强的耐药性,而且一旦感染,几乎无法治愈。
当然,无论答案如何,现在人类世界中已经出现了“超级真菌”,所以,未来也仍然需要对它进行深入研究,想办法阻止它的继续传播。

那么,在我国有“超级真菌”的感染病例吗?我们在日常生活中又该如何防范呢?
答案当然是有的,我国第一次出现“超级真菌”的感染病例,是在2018年5月,从当时的报道来看,感染者是一名因为肾病和高血压入院治疗的76岁患者,在那之后,我国陆续又发现了多名“超级真菌”感染者,截止到目前,我国累计“超级真菌”感染者已有18人。
来自中国工程院的科学家廖万清介绍:当患者感染“超级真菌”后,主要表现症状是不明原因的高烧,并患有器官衰竭和呼吸衰竭,在临床治疗方面,由于“超级真菌”的耐药性,所以,基本上各种治疗对它都是无效的,患者治愈率非常低。
因此,在预防“超级真菌”感染方面,如果是在医院环境下,需要确保医院环境的整洁卫生,尤其是病人的治疗、居住环境,一定要杜绝任何污染源,只有这样,才可以避免“超级真菌”在医院内部传播。

而对于健康人群来说,想要远离“超级真菌”,只需要保持一个良好的卫生习惯,勤洗手就可以了,这样就可以有效杜绝多种致病菌的感染。
此外,有关专家表示:虽然如今新冠疫情和前阵子多国爆发的“猴痘”,的确让不少人都“谈菌色变”,但其实因为“超级真菌”的特殊性,它在全球造成爆发性流行的概率,是非常低的,所以使者认为,大家只需要用平常心对待就可以了,不用对此太担心。